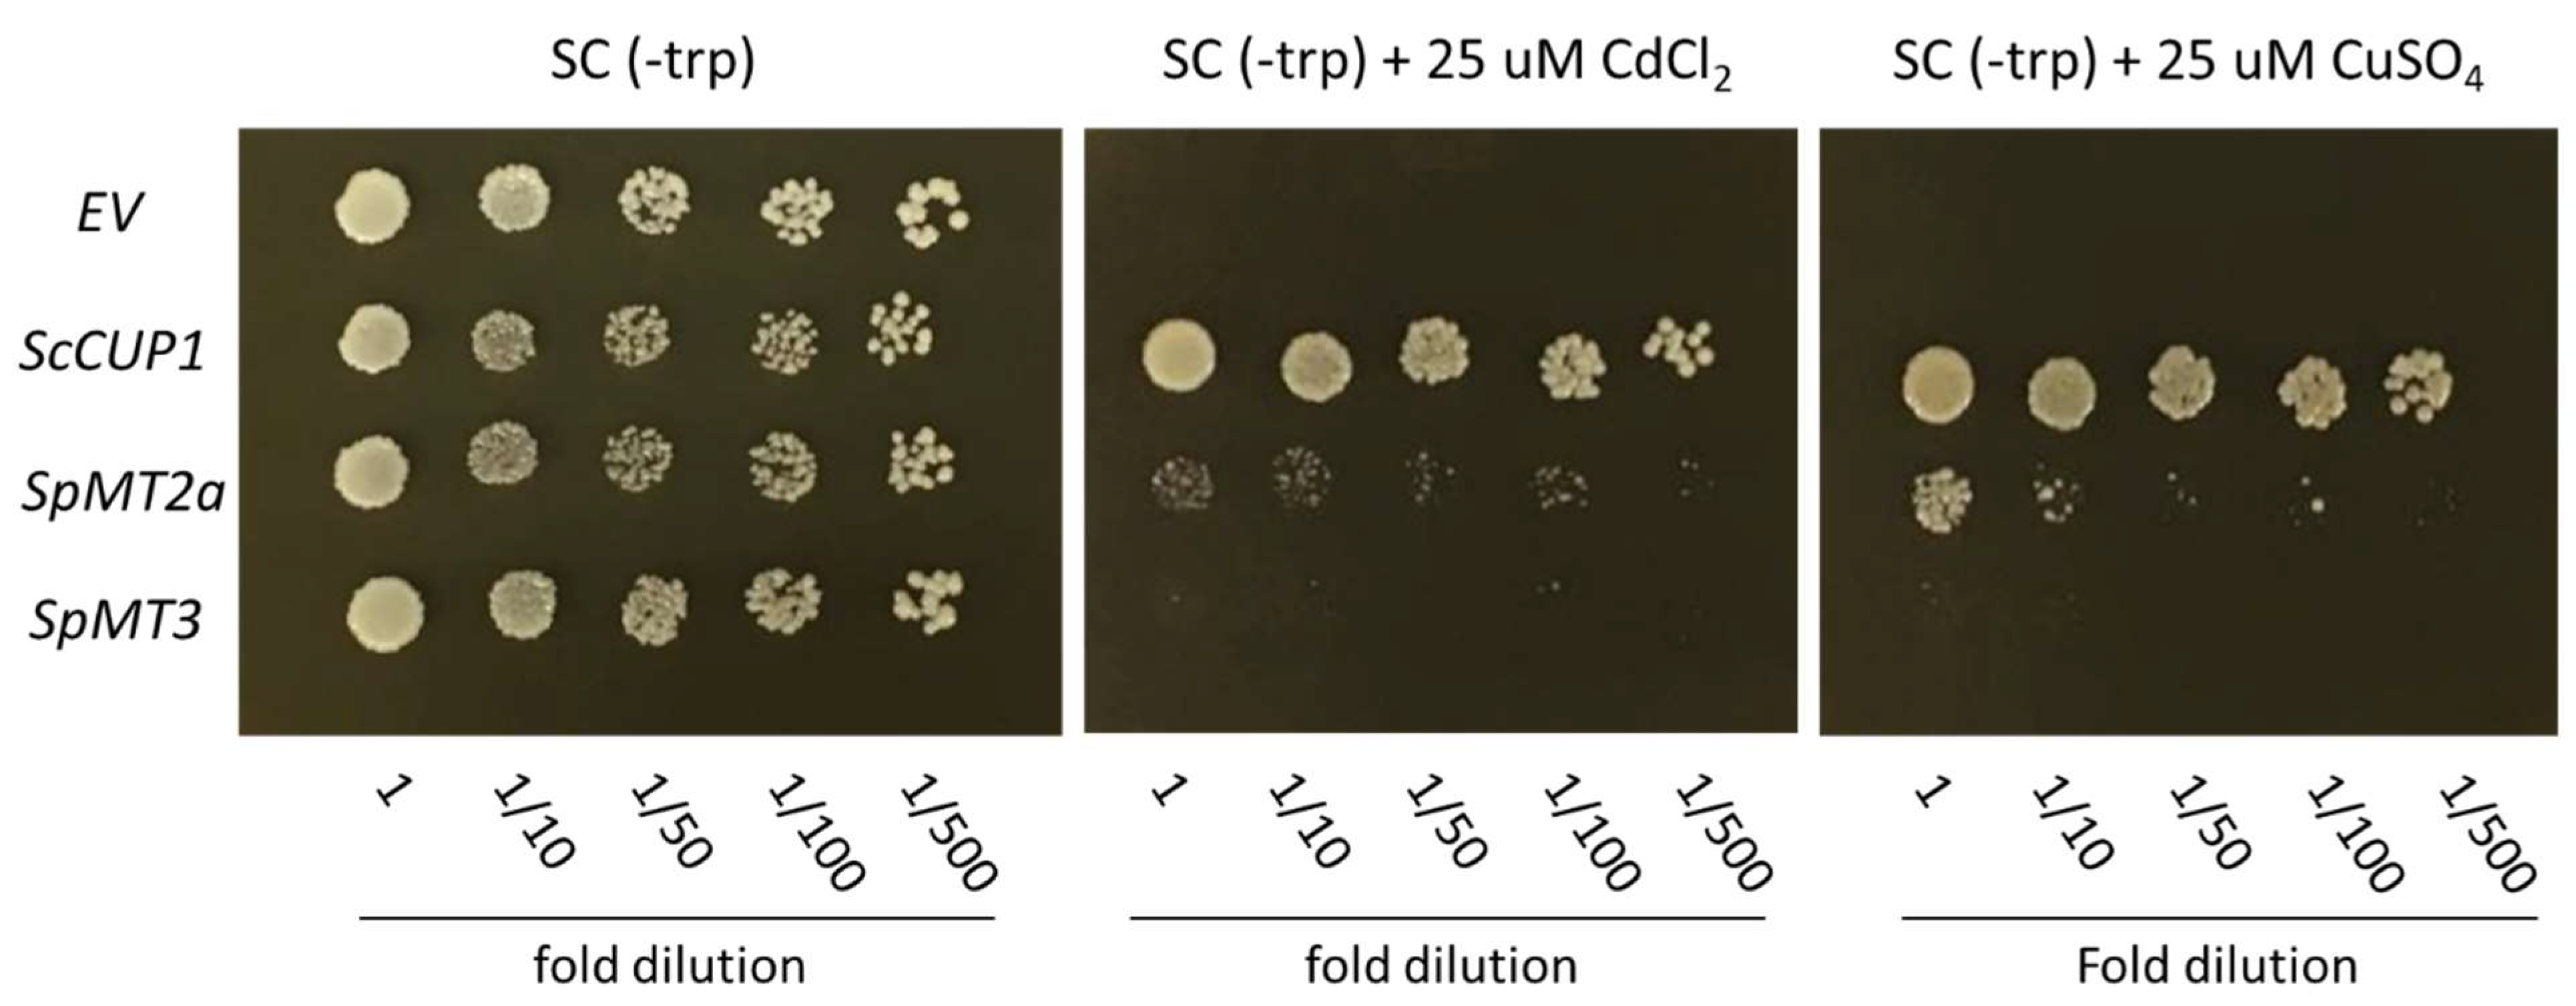
Plants 12 00125 g004

Examination of the Metallothionein Gene Family in Greater Duckweed Spirodela polyrhiza
Abstract
1. Introduction
2. Results
2.1. Identification and Annotation of Putative S. polyrhiza MT-like Genes
2.2. Transcriptional Response to Cadmium and Copper Stresses
2.3. Copper and Cadmium Tolerance Conferred by the Heterologous Expression of SpMT2b in S. cerevisiae
3. Discussion
4. Materials and Methods
4.1. Plant Material and Culture Conditions
4.2. Identification and Annotation of Putative MT Genes
4.3. RT-PCR Analysis of S. polyrhiza MT Gene Expression
4.4. Heterologous Expression of SpMT2a and SpMT3
5. Conclusions
Supplementary Materials
Author Contributions
Funding
Data Availability Statement
Acknowledgments
Conflicts of Interest
References
- Nielson, K.B.; Atkin, C.L.; Winge, D.R. Distinct metal-binding configurations in metallothionein. J. Biol. Chem. 1985, 260, 5342–5350. [Google Scholar] [CrossRef]
- Krężel, A.; Maret, W. The bioinorganic chemistry of mammalian metallothioneins. Chem. Rev. 2021, 121, 14594–14648. [Google Scholar] [CrossRef]
- Cobbett, C.; Goldsbrough, P. Phytochelatins and metallothioneins: Roles in heavy metal detoxification and homeostasis. Annu. Rev. Plant Biol. 2002, 53, 159–182. [Google Scholar] [CrossRef] [PubMed]
- Guo, W.J.; Meetam, M.; Goldsbrough, P.B. Examining the specific contributions of individual Arabidopsis metallothioneins to copper distribution and metal tolerance. Plant Physiol. 2008, 146, 1697–1706. [Google Scholar] [CrossRef]
- Acosta, K.; Appenroth, K.J.; Borisjuk, L.; Edelman, M.; Heinig, U.; Jansen, M.A.K.; Oyama, T.; Pasaribu, B.; Schubert, I.; Sorrels, S.; et al. Return of the Lemnaceae: Duckweed as a model plant system in the genomics and postgenomics era. Plant Cell 2021, 33, 3207–3234. [Google Scholar] [CrossRef] [PubMed]
- Vu, G.T.H.; Fourounjian, P.; Wang, W.; Cao, X.H. Future prospects of duckweed research and applications. In The Duckweed Genomes; Cao, X.H., Fourounjian, P., Wang, W., Eds.; Springer International Publishing: Cham, Switzerland, 2020; pp. 179–185. [Google Scholar]
- Gupta, C.; Prakash, D. Duckweed: An effective tool for phyto-remediation. Toxicol. Environ. Chem. 2013, 95, 1256–1266. [Google Scholar] [CrossRef]
- Vardhan, K.H.; Kumar, P.S.; Panda, R.C. A review on heavy metal pollution, toxicity and remedial measures: Current trends and future perspectives. J. Mol. Liq. 2019, 290, 111197. [Google Scholar] [CrossRef]
- Ali, Z.; Waheed, H.; Kazi, A.G.; Hayat, A.; Ahmad, M. Chapter 16—Duckweed: An efficient hyperaccumulator of heavy metals in water bodies. In Plant Metal Interaction; Ahmad, P., Ed.; Elsevier: Amsterdam, The Netherlands, 2016; pp. 411–429. [Google Scholar]
- Xu, H.; Yu, C.; Xia, X.; Li, M.; Li, H.; Wang, Y.; Wang, S.; Wang, C.; Ma, Y.; Zhou, G. Comparative transcriptome analysis of duckweed (Landoltia punctata) in response to cadmium provides insights into molecular mechanisms underlying hyperaccumulation. Chemosphere 2018, 190, 154–165. [Google Scholar] [CrossRef]
- Chen, Y.; Zhao, X.; Li, G.; Kumar, S.; Sun, Z.; Li, Y.; Guo, W.; Yang, J.; Hou, H. Genome-wide identification of the nramp gene family in Spirodela polyrhiza and expression analysis under cadmium Stress. Int. J. Mol. Sci. 2021, 22, 6414. [Google Scholar] [CrossRef]
- Chyan, C.L.; Lee, T.T.; Liu, C.P.; Yang, Y.C.; Tzen, J.T.; Chou, W.M. Cloning and expression of a seed-specific metallothionein-like protein from sesame. Biosci. Biotechnol. Biochem. 2005, 69, 2319–2325. [Google Scholar] [CrossRef]
- Ekperusi, A.O.; Sikoki, F.D.; Nwachukwu, E.O. Application of common duckweed (Lemna minor) in phytoremediation of chemicals in the environment: State and future perspective. Chemosphere 2019, 223, 285–309. [Google Scholar] [CrossRef]
- Ceschin, S.; Crescenzi, M.; Iannelli, M.A. Phytoremediation potential of the duckweeds Lemna minuta and Lemna minor to remove nutrients from treated waters. Environ. Sci. Pollut. Res. 2020, 27, 15806–15814. [Google Scholar] [CrossRef]
- Liu, Y.; Xu, H.; Yu, C.; Zhou, G. Multifaceted roles of duckweed in aquatic phytoremediation and bioproducts synthesis. GCB Bioenergy 2021, 13, 70–82. [Google Scholar] [CrossRef]
- Yoksan, R.; Boontanimitr, A.; Klompong, N.; Phothongsurakun, T. Poly(lactic acid)/thermoplastic cassava starch blends filled with duckweed biomass. Int. J. Biol. Macromol. 2022, 203, 369–378. [Google Scholar] [CrossRef]
- Liu, Y.; Sanguanphun, T.; Yuan, W.; Cheng, J.J.; Meetam, M. The biological responses and metal phytoaccumulation of duckweed Spirodela polyrhiza to manganese and chromium. Environ. Sci. Pollut. Res. 2017, 24, 19104–19113. [Google Scholar] [CrossRef]
- Hu, D.; Cheng, M.; Hu, K.; Zhang, W.; Yang, Y.; Xu, Q. Evaluation of cobalt hyperaccumulation and tolerance potential of the duckweed (Lemna minor L.). Ecotoxicol. Environ. Saf. 2019, 179, 79–87. [Google Scholar] [CrossRef]
- Chaudhary, E.; Sharma, P. Chromium and cadmium removal from wastewater using duckweed—Lemna gibba L. and ultrastructural deformation due to metal toxicity. Int. J. Phytoremediation 2019, 21, 279–286. [Google Scholar] [CrossRef]
- Wang, X.; Zhang, B.; Wu, D.; Hu, L.; Huang, T.; Gao, G.; Huang, S.; Wu, S. Chemical forms governing Cd tolerance and detoxification in duckweed (Landoltia punctata). Ecotoxicol. Environ. Saf. 2021, 207, 111553. [Google Scholar] [CrossRef]
- Murphy, A.; Taiz, L. Comparison of metallothionein gene expression and nonprotein thiols in ten Arabidopsis ecotypes. Correlation with copper tolerance. Plant Physiol. 1995, 109, 945–954. [Google Scholar] [CrossRef]
- Wang, W.; Haberer, G.; Gundlach, H.; Gläßer, C.; Nussbaumer, T.; Luo, M.C.; Lomsadze, A.; Borodovsky, M.; Kerstetter, R.A.; Shanklin, J.; et al. The Spirodela polyrhiza genome reveals insights into its neotenous reduction fast growth and aquatic lifestyle. Nat. Commun. 2014, 5, 3311. [Google Scholar] [CrossRef]
- An, D.; Zhou, Y.; Li, C.; Xiao, Q.; Wang, T.; Zhang, Y.; Wu, Y.; Li, Y.; Chao, D.Y.; Messing, J.; et al. Plant evolution and environmental adaptation unveiled by long-read whole-genome sequencing of Spirodela. Proc. Natl. Acad. Sci. USA 2019, 116, 18893–18899. [Google Scholar] [CrossRef] [PubMed]
- Harkess, A.; McLoughlin, F.; Bilkey, N.; Elliott, K.; Emenecker, R.; Mattoon, E.; Miller, K.; Czymmek, K.; Vierstra, R.D.; Meyers, B.C.; et al. Improved Spirodela polyrhiza genome and proteomic analyses reveal a conserved chromosomal structure with high abundance of chloroplastic proteins favoring energy production. J. Exp. Bot. 2021, 72, 2491–2500. [Google Scholar] [CrossRef] [PubMed]
- Michael, T.P.; Bryant, D.; Gutierrez, R.; Borisjuk, N.; Chu, P.; Zhang, H.; Xia, J.; Zhou, J.; Peng, H.; El Baidouri, M.; et al. Comprehensive definition of genome features in Spirodela polyrhiza by high-depth physical mapping and short-read DNA sequencing strategies. Plant J. 2017, 89, 617–635. [Google Scholar] [CrossRef] [PubMed]
- Hoang, P.N.T.; Michael, T.P.; Gilbert, S.; Chu, P.; Motley, S.T.; Appenroth, K.J.; Schubert, I.; Lam, E. Generating a high-confidence reference genome map of the Greater Duckweed by integration of cytogenomic, optical mapping, and Oxford Nanopore technologies. Plant J. 2018, 96, 670–684. [Google Scholar] [CrossRef]
- Park, H.; Park, J.H.; Lee, Y.; Woo, D.U.; Jeon, H.H.; Sung, Y.W.; Shim, S.; Kim, S.H.; Lee, K.O.; Kim, J.-Y.; et al. Genome of the world’s smallest flowering plant, Wolffia australiana, helps explain its specialized physiology and unique morphology. Commun. Biol. 2021, 4, 900. [Google Scholar] [CrossRef]
- An, D.; Li, C.; Zhou, Y.; Wu, Y.; Wang, W. Genomes and transcriptomes of duckweeds. Front. Chem. 2018, 6, 230. [Google Scholar] [CrossRef]
- Guo, W.-J.; Bundithya, W.; Goldsbrough, P.B. Characterization of the Arabidopsis metallothionein gene family: Tissue-specific expression and induction during senescence and in response to copper. New Phytol. 2003, 159, 369–381. [Google Scholar] [CrossRef]
- Kawashima, I.; Kennedy, T.D.; Chino, M.; Lane, B.G. Wheat Ec metallothionein genes. Like mammalian Zn2+ metallothionein genes, wheat Zn2+ metallothionein genes are conspicuously expressed during embryogenesis. Eur. J. Biochem. 1992, 209, 971–976. [Google Scholar] [CrossRef]
- Ren, Y.; Liu, Y.; Chen, H.; Li, G.; Zhang, X.; Zhao, J. Type 4 metallothionein genes are involved in regulating Zn ion accumulation in late embryo and in controlling early seedling growth in Arabidopsis. Plant Cell Environ. 2012, 35, 770–789. [Google Scholar] [CrossRef]
- Fourounjian, P.; Slovin, J.; Messing, J. Flowering and seed production across the Lemnaceae. Int. J. Mol. Sci. 2021, 22, 2733. [Google Scholar] [CrossRef]
- Zhou, J.; Goldsbrough, P.B. Structure, organization and expression of the metallothionein gene family in Arabidopsis. Mol. Gen. Genet 1995, 248, 318–328. [Google Scholar] [CrossRef] [PubMed]
- Xu, X.; Duan, L.; Yu, J.; Su, C.; Li, J.; Chen, D.; Zhang, X.; Song, H.; Pan, Y. Characterization analysis and heavy metal-binding properties of CsMTL3 in Escherichia coli. FEBS Open Bio 2018, 8, 1820–1829. [Google Scholar] [CrossRef] [PubMed]
- Schiller, M.; Hegelund, J.N.; Pedas, P.; Kichey, T.; Laursen, K.H.; Husted, S.; Schjoerring, J.K. Barley metallothioneins differ in ontogenetic pattern and response to metals. Plant Cell Environ. 2014, 37, 353–367. [Google Scholar] [CrossRef] [PubMed]
- Hsieh, H.M.; Liu, W.K.; Huang, P.C. A novel stress-inducible metallothionein-like gene from rice. Plant Mol. Biol. 1995, 28, 381–389. [Google Scholar] [CrossRef]
- Pakdee, O.; Songnuan, W.; Panvisavas, N.; Pokethitiyook, P.; Yokthongwattana, K.; Meetam, M. Functional characterization of metallothionein-like genes from Physcomitrella patens: Expression profiling, yeast heterologous expression, and disruption of PpMT1.2a gene. Planta 2019, 250, 427–443. [Google Scholar] [CrossRef]
- Hegelund, J.N.; Schiller, M.; Kichey, T.; Hansen, T.H.; Pedas, P.; Husted, S.; Schjoerring, J.K. Barley metallothioneins: MT3 and MT4 are localized in the grain aleurone layer and show differential zinc binding. Plant Physiol. 2012, 159, 1125–1137. [Google Scholar] [CrossRef]
- Wong, H.L.; Sakamoto, T.; Kawasaki, T.; Umemura, K.; Shimamoto, K. Down-regulation of metallothionein, a reactive oxygen scavenger, by the small GTPase OsRac1 in rice. Plant Physiol. 2004, 135, 1447–1456. [Google Scholar] [CrossRef]
- Xue, T.; Li, X.; Zhu, W.; Wu, C.; Yang, G.; Zheng, C. Cotton metallothionein GhMT3a, a reactive oxygen species scavenger, increased tolerance against abiotic stress in transgenic tobacco and yeast. J. Exp. Bot. 2009, 60, 339–349. [Google Scholar] [CrossRef]
- Kumar, S.; Stecher, G.; Li, M.; Knyaz, C.; Tamura, K. MEGA X: Molecular evolutionary genetics analysis across computing platforms. Mol. Biol. Evol. 2018, 35, 1547–1549. [Google Scholar] [CrossRef]
- Mumberg, D.; Muller, R.; Funk, M. Yeast vectors for the controlled expression of heterologous proteins in different genetic backgrounds. Gene 1995, 156, 119–122. [Google Scholar] [CrossRef]

| Gene | Transcript | Location | No. of a.a. | No. of Cys |
|---|---|---|---|---|
| MT2a | Spipo0G0112500 | Chr. 7 | 78 | 14 |
| MT2b | Spipo6G0071500 | Chr. 5 | 60 | 5 |
| MT3 | Spipo14G0028700 | Chr. 9 | 65 | 10 |
| MT4 | Spipo0G0175800 | Chr. 18 | 82 | 17 |
| Primers | Sequence (5′ → 3′) | Expected Amplicon Size (bp) | Annealing Temperature (°C) |
|---|---|---|---|
| Primers for RT-PCR Analysis | |||
| SpMT2a-F | TGACGAGAAGATGACCACCA | 148 | 56 |
| SpMT2a-R | TCATTTGCAGGTGCAGGGAT | ||
| SpMT2b-F | ATGTCTTGCACCAGCGGGAAA | 134 | 56 |
| SpMT2b-R | GCAGCGACCATCTCGAACGACTC | ||
| SpMT3-F | ACCCAGTGCGTGAAGAAGGGCAA | 162 | 56 |
| SpMT3-R | TCAATGGCCGCAGGAGCAGGTGG | ||
| SpMT4-F | GACGTAGGAGCGACGCGAGG | 188 | 56 |
| SpMT4-R | CCAACGCCAGAGGAAGCACC | ||
| SpACT-F | GCGACATCAAGGAGAAGCTG | 213 | 56 |
| SpACT-R | AGTTGTAGGTGGTCTCGTGG | ||
| Primers for heterologous expression | |||
| SpMT2a-ORF-F | GAAGATGTCTTGCTGCGGAG | 258 | 58 |
| SpMT2a-ORF-R | CCTTCATACAGGAAGCGTCC | ||
| SpMT3-ORF-F | CCATGTCGAGCTGCGGCAACT | 203 | 58 |
| SpMT3-ORF-R | CGCTCAATGGCCGCAGGA | ||
Disclaimer/Publisher’s Note: The statements, opinions and data contained in all publications are solely those of the individual author(s) and contributor(s) and not of MDPI and/or the editor(s). MDPI and/or the editor(s) disclaim responsibility for any injury to people or property resulting from any ideas, methods, instructions or products referred to in the content. |
© 2022 by the authors. Licensee MDPI, Basel, Switzerland. This article is an open access article distributed under the terms and conditions of the Creative Commons Attribution (CC BY) license (https://creativecommons.org/licenses/by/4.0/).
Share and Cite
Pakdee, O.; Tshering, S.; Pokethitiyook, P.; Meetam, M. Examination of the Metallothionein Gene Family in Greater Duckweed Spirodela polyrhiza. Plants 2023, 12, 125. https://doi.org/10.3390/plants12010125
Pakdee O, Tshering S, Pokethitiyook P, Meetam M. Examination of the Metallothionein Gene Family in Greater Duckweed Spirodela polyrhiza. Plants. 2023; 12(1):125. https://doi.org/10.3390/plants12010125
Chicago/Turabian StylePakdee, Orathai, Shomo Tshering, Prayad Pokethitiyook, and Metha Meetam. 2023. "Examination of the Metallothionein Gene Family in Greater Duckweed Spirodela polyrhiza" Plants 12, no. 1: 125. https://doi.org/10.3390/plants12010125
APA StylePakdee, O., Tshering, S., Pokethitiyook, P., & Meetam, M. (2023). Examination of the Metallothionein Gene Family in Greater Duckweed Spirodela polyrhiza. Plants, 12(1), 125. https://doi.org/10.3390/plants12010125

